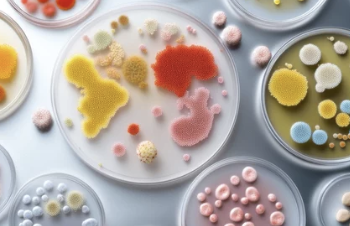
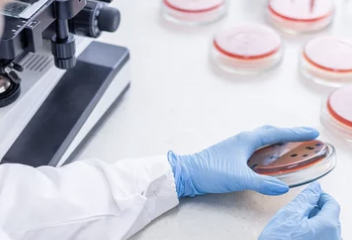

혀에 백태가 끼는 이유 – 정상일까? 건강 이상 신호일까?
- 치아건강
- 2025. 5. 21. 12:17
혀에 백태가 끼는 이유 – 정상일까? 건강 이상 신호일까?
아침에 일어나 거울을 보면 혀 위에 하얀 막처럼 뿌옇게 덮여 있는 백태(白苔),
가볍게 닦아내면 없어지기도 하지만 때로는 두껍고 잘 지워지지 않거나, 입 냄새의 원인이 되기도 합니다.
혀의 백태는 단순한 위생 문제일 수도 있지만, 소화기 질환, 면역력 저하, 구강염증, 곰팡이 감염 등 건강 상태와도 밀접하게 연관되어 있어 그 원인을 잘 구분해야 합니다.
이번 글에서는 혀에 백태가 생기는 주요 원인 8가지, 정상 백태 vs 이상 백태 구별법, 자가 관리 방법과 예방 팁까지 자세히 정리해드립니다.
1. 혀 백태란?

혀 표면은 돌기 모양의 유두로 구성되어 있는데, 이 위에 탈락된 점막세포, 음식물 찌꺼기, 세균, 진균 등이 쌓여 하얗게 보이는 것이 바로 ‘백태’입니다.
정상인도 있을 수 있으나, 지속되거나 두꺼워지고 색이 변하면 건강 이상 신호일 수 있습니다.
2. 정상 백태 vs 비정상 백태 구분법



구분 정상 백태 비정상 백태 (질환 의심)
| 색깔 | 연한 흰색 | 진한 백색, 황색, 회색 |
| 두께 | 얇고 고르게 분포 | 두껍거나 불균형, 한쪽만 두꺼움 |
| 제거 | 물이나 칫솔로 쉽게 제거 | 잘 지워지지 않거나 금방 다시 생김 |
| 냄새 | 무취 or 약간 | 입냄새 동반, 쓴맛 |
| 기타 증상 | 없음 | 입안 통증, 구취, 미각 저하, 염증 동반 |
✅ 정상이더라도 아침에만 잠시 생겼다가 양치 후 사라지면 무관,
✅ 그러나 지속되거나 통증, 냄새가 심하다면 진료 필요
3. 혀에 백태가 끼는 주요 원인 8가지



✅ 1) 구강 위생 불량
- 칫솔질은 하지만 혀 클리너 사용 안 하면 백태가 점점 두꺼워짐
- 특히 흡연자, 커피 많이 마시는 사람에게 자주 발생
✅ 2) 수분 부족 (구강건조증)
- 침 분비가 줄어들면 세균이 쉽게 증식
- 입이 마르고 혀가 갈라지는 느낌이 함께 나타날 수 있음
✅ 3) 입호흡 습관
- 코가 막히거나 습관적으로 입으로 숨 쉬는 경우
- 혀가 건조해지고 백태 + 입냄새로 이어짐
✅ 4) 위장 기능 저하
- 한의학에서는 백태가 위장의 습열(濕熱) 또는 냉기(寒氣)로 본다고 해요
- 소화불량, 위염, 역류성 식도염 환자에게 흔히 동반됨
✅ 5) 곰팡이 감염 (구강칸디다증)

- 혀 백태가 치즈처럼 두껍고, 벗기면 출혈
- 면역력이 떨어졌을 때 잘 생김 (항생제 복용 후, 당뇨병, 암환자 등)
✅ 6) 흡연과 과도한 커피 섭취
- 담배 속 타르, 커피 속 색소가 혀에 침착되어 백태 악화
- 구강 건조도 유발 → 입냄새 심해짐
✅ 7) 항생제/약물 부작용
- 항생제 복용 후 입안 유익균이 줄어들어 칸디다균 증식
- 스테로이드 흡입기 사용 후에도 백태 생길 수 있음
✅ 8) 면역력 저하, 스트레스
- 과로, 불면, 스트레스로 인한 면역 저하가 백태를 악화
- 특히 혀끝이 갈라지거나 마른 증상과 함께 나타날 수 있음
4. 혀 백태 관리 및 제거 방법



✅ STEP 1. 아침에 혀 클리너 or 부드러운 칫솔로 살살 닦기
- 하루 1~2회, 혀뿌리부터 앞쪽 방향으로 부드럽게
- 너무 세게 닦으면 유두 손상 → 더 많은 백태 유발
✅ STEP 2. 충분한 수분 섭취
- 입 마르는 순간 세균이 증식 → 수시로 물 마시기
- 특히 커피나 술 섭취 후엔 물로 입 헹구기
✅ STEP 3. 구강청결제 사용 (항균 성분 있는 제품)
- 클로르헥시딘, 시트르산 등 항균 효과 있는 가글로 보조
- 장기 사용은 유익균까지 제거할 수 있어 주의
✅ STEP 4. 입호흡 교정 or 코 호흡 훈련
- 수면 중 입호흡 막는 입마개, 테이프 활용
- 만성 코막힘 있으면 이비인후과 진료 병행
✅ STEP 5. 위장 개선 식단
- 밀가루, 기름진 음식, 카페인 줄이기
- 생강차, 매실, 식이섬유 많은 식단으로 장 건강 → 구강 개선
5. 병원에 가야 하는 경우



- 백태가 2주 이상 지속
- 혀에 통증, 갈라짐, 염증 동반
- 입안이 따갑고, 음식이 쓴맛으로 느껴짐
- 백태 제거하면 출혈이 생길 정도로 두꺼움
- 항생제 복용 후 혀가 하얗게 변한 경우
✅ 구강내과, 이비인후과, 한의원 등에서 접근 가능